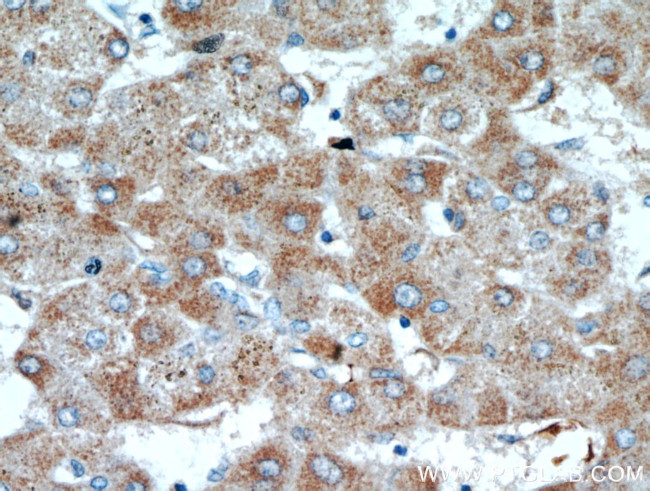
SCO2 Antibody in Immunohistochemistry (Paraffin) (IHC (P))

Search
Proteintech
SCO2 Polyclonal Antibody
{{$productOrderCtrl.translations['antibody.pdp.commerceCard.promotion.promotions']}}
{{$productOrderCtrl.translations['antibody.pdp.commerceCard.promotion.viewpromo']}}
{{$productOrderCtrl.translations['antibody.pdp.commerceCard.promotion.promocode']}}: {{promo.promoCode}} {{promo.promoTitle}} {{promo.promoDescription}}. {{$productOrderCtrl.translations['antibody.pdp.commerceCard.promotion.learnmore']}}







Please note: We are reviewing Western blot images included in the antibody testing data in our catalog, including those provided by third parties. Unless expressly labeled or annotated as “raw-unedited”, Western blot images included in the antibody testing data in our catalog may have been edited, optimized or otherwise adjusted for presentation.
产品信息
21223-1-AP
种属反应
已发表种属
宿主/亚型
分类
类型
抗原
偶联物
形式
浓度
规格
纯化类型
保存液
内含物
保存条件
运输条件
产品详细信息
Immunogen sequence: MLLLTRSPT AWHRLSQLKP RVLPGTLGGQ ALHLRSWLLS RQGPAETGGQ GQPQGPGLRT RLLITGLFGA GLGGAWLALR AEKERLQQQK RTEALRQAAV GQGDFHLLDH RGRARCKADF RGQWVLMYFG FTHCPDICPD ELEKLVQVVR QLEAEPGLPP VQPVFITVDP ERDDVEAMAR YVQDFHPRLL GLTGSTKQVA QASHSYRVYY NAGPKDEDQD YIVDHSIAIY LLNPDGLFTD YYGRSRSAEQ ISDSVRRHMA AFRSVLS (1-266 aa encoded by BC102025)
靶标信息
Synthesis of cytochrome c oxidase 2 was initially identified in yeast as one of two cytochrome c oxidase (COX) assembly proteins that enable the assembly of cytochrome c holoenzyme, a complex that catalyzes the transfer of reducing equivalents from cytochrome c to molecular oxygen and pumps protons across the inner mitochondrial membrane. Like their yeast homologs, the function of both SCO2 and SCO1 are dependent on copper ion binding. Recent studies suggest that SCO2 expression is regulated by p53, so that a decrease in p53 expression, such as in numerous tumors and cells lines, the drop in SCO2 expression leads to a shift from normal aerobic respiration towards the production of glycolytic ATP. Defects in the SCO2 protein are also associated with fatal infantile cardioencephalomyopathy and COX deficiency.
仅用于科研。不用于诊断过程。未经明确授权不得转售。
生物信息学
蛋白别名: Cytochrome c oxidase assembly factor SCO2; Platelet-derived endothelial cell growth factor; SCO cytochrome c oxidase assembly protein 2; SCO cytochrome oxidase deficient homolog 2; SCO2; SCO2, cytochrome c oxidase assembly protein; Thymidine phosphorylase; unnamed protein product
基因别名: CEMCOX1; ECGF1; Gliostatin; MC4DN2; MYP6; PD-ECGF; SCO1L; SCO2; TdRPase; TP; TYMP
UniProt ID: (Human) O43819
Entrez Gene ID: (Human) 9997